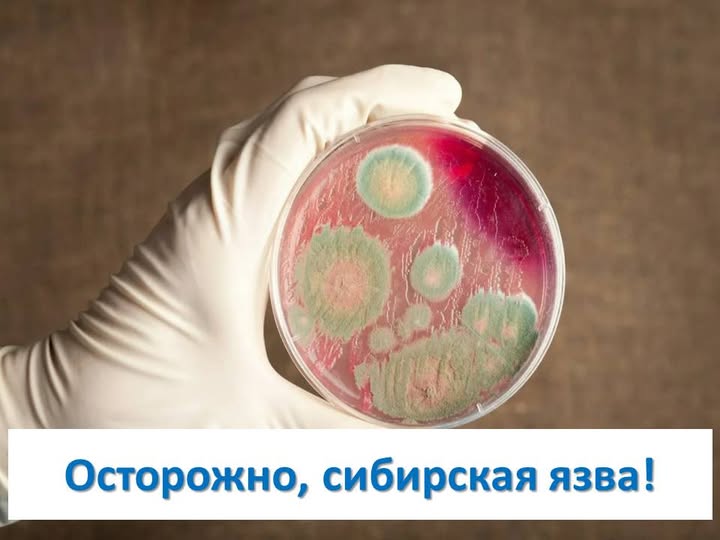

Күйдіргі — адам денсаулығына айтарлықтай қауіп төндіретін аса қауіпті жұқпалы ауру. Ауру көбінесе терінің зақымдануы (карбункул) түрінде байқалады, алайда уақытылы ем көрсетілмеген жағдайда сепсиске және өлімге әкелетін жайылған түріне айналуы мүмкін.
Аурудың негізгі көзі — шөпқоректі жануарлар.
Күйдіргімен бірнеше жолмен жұқтыруға болады:
Аурудың жасырын кезеңі 2-ден 14 күнге дейін созылады. Симптомдары жұқтыру жолына және ауру түріне байланысты әр түрлі болуы мүмкін.
Ақмола облысының санитариялық-эпидемиологиялық бақылау департаментінің эпидемиологтары ескертеді: өзіңізді және жақындарыңызды қорғау үшін мына қарапайым, бірақ маңызды ережелерді ұстаныңыз:
Денсаулығыңызды сақтаңыз және алдын алу шараларын елемеңіз. Ауруға күдік туындаған жағдайда дереу дәрігерге жүгініңіз!

Ақпарат көзі : https://www.gov.kz/memleket/entities/departament-kkbtu-akmolinsk/press/news/details/1031959?lang=kk

Жауап қалдыру